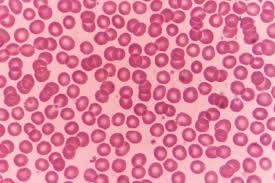

Cocci (bacteria) 203

Calcium oxalate crystals 201
Remember that they can also have an oval or bowtie shape

Hookworm Adult 217
Look at how small they are

Tick: Black Legged Deer 238
(Female)

Roundworm Egg 231

Heartworm Microfilaria 216

Ear Mite 206

Flea Tapeworm Egg 210
Red blood cell 228

Calcium oxalate crystals 201
Notice the “X” at the top

Heartworm Adult 215

Tick: Lone Star 240
(Male)

Taenia Tapeworm segment 235
Notice the one ovary and “tape” like shape

Horse Strongyles 220

Tick: Brown Dog 239
(Male)

Taenia Tapeworm 236

Mosquito: Larvae 225

Whipworm 242

Hookworm Adult 217

Flea Tapeworm Segment 211

Blow Fly 200

Lice: Sucking 222
Notice the head shape

Flea 213

Tick: Brown Dog 239
(Female)